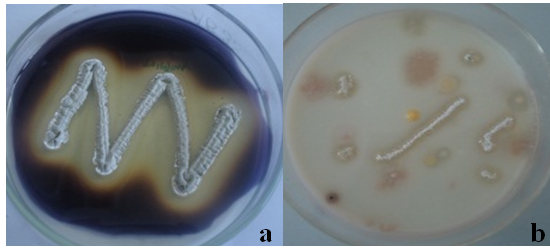

Int J Pharm Pharm Sci, Vol 7, Issue 2, 84-88Original Article
ANTIFUNGAL ACTIVITY OF FIVE STRAINS OF SOIL MICROORGANISMS ISOLATED FROM TANGKUBAN PERAHU MOUNTAIN
UKAN SUKANDAR1, DESAK GEDE SRI ANDAYANI2, ELIN YULINAH SUKANDAR3, I KETUT ADNYANA3
1Chemical Engineering, Institut Teknologi Bandung, Jl. Ganesa 10, Bandung 40132, Indonesia, 2Research Center for Chemistry, Indonesian Institute of Sciences, Puspiptek, Serpong 15314, Indonesia, 3The School of Pharmacy, Institut Teknologi Bandung, Jl Ganesa 10, Bandung 40132, Indonesia.
Email: usukandar@che.itb.ac.id
Received: 26 Oct 2014 Revised and Accepted: 25 Nov 2014
ABSTRACT
Objective: The objective of this research was production of antifungal by microorganism isolated from soil of Tangkuban Perahu mountain.
Methods: The microorganisms were isolated from soil by the serial dilution method and identified by observing morphological, biochemical and molecular characteristics.
Production of antifungal metabolites was done by fermentation. Screening for bioactivity of isolates was done by testing the fermentation broth against Microsforum gypseum, the metabolite was extracted with ethyl acetate. Antifungal activities from the ethyl acetate extract were tested by agar diffusion and microdillution methods.
Results: Five strains of microorganisms were isolated from soil taken from Tangkuban Perahu mountain and were investigated in this study, designated TP1, TP2, TP3, TP4, and TP5, respectively. These isolates were shown to be closely related to Nocardia sp. YIM 65630 GU367167.1 (90%), Streptomyces galbus NR 026178.1 (99%), Aspergillus unguis FJ878626 (86%), Paecilomyces marquandii FJ765026 (100%), and Nocardia niigatensis NR 043916.1 (95%). The result of the bioactive screening showed that all isolates had antifungal activities, with the range of diameter of inhibition of 7-18 mm against M. gypseum, and TP2 has diameter of inhibition of 18 ± 0.05 mm.
Conclusion: The highest antifungal activity showed by TP2 strain. The ethyl acetate extract of TP2 strain against Microsporum gypseum has the MIC of 4.7 µg/ml and diameter of inhibition was 36 ± 0.10 mm.
Keywords: Antifungal activities, Identification, Fermentation, Ethyl acetate extract.
INTRODUCTION
Soil microorganisms from the group of Actinomycetes are well accepted to be the best producer of antibiotics. The study of the Actinomycetes group through isolation, identification, and screening for potential bioactivity is expected to provide further knowledge about the diversity of the genera and species and to render the potential to find new antibiotics. Volcanic soil that is rich in sulfur is a potential source of medicinal raw materials that come from nature. Actinomycetes and fungi that are found around such an extreme area have adapted to utilize sulfur as nutrition, while at the same time utilizing this as a defense against other microorganisms. Fermentation technology can be used to produce such secondary metabolites of microorganisms to increase the metabolite product for exploitation by the pharmaceutical industry. To date, antibiotics have been used as a treatment against infection diseases that are caused by resistant and pathogenic bacteria, fungi and viruses. The isolation of new microorganisms and their new metabolites remains sought after because antibiotic resistance is becoming significance. Attempts have been made by various researchers to achieve these objectives. Antibiotics are secondary metabolites that are synthesized by a specific microorganism, while it is not necessary for that organism to live and grow. Various secondary metabolites are produced by Actinomycetes and fungi groups around volcanic soil. Further study of those microorganisms can uncover the potential of such products to be exploited for the benefit of humankind [1,2]. TP1 strain belongs to the Nocardia species and showed an antibacterial activity against sensitive and resistant bacteria [3]. TP2 strain produced phenylacetic acid that showed antibacterial and anticancer activity [4]. The objective of this research was production of antifungal by microorganism isolated from soil of Tangkuban Perahu mountain. Of the five investigated strains, TP2 showed the highest antifungal activity against Microsporum gypseum.
MATERIAL AND METHODS
Isolation of Actinomycetes and fungi
One gram of dried soil sample was taken in 100 ml of sterile distilled water and mixed thoroughly in a shaker for 15 min at 120 rpm. One ml of different aqueous dilutions (10-3, 10-4, 10-5, 10-6, 10-7 and 10-8) of the suspension was applied onto plates and 16 ml of melted PDA medium at around 400C was added to it. After gently rotating, the plates were incubated at 280C for 7 to 14 days. Selected colonies (rough, chalky) of Actinomycetes and fungi were transferred from the mixed culture of the plates to respective agar plates and incubated at 280C for 7 days. The plates containing pure cultures were transferred and stored at 40C in the shape of slant agar [5].
Taxonomical characterization
The cultural characteristics of pure isolates in various media were recorded after incubation for 7 to 14 days at 280C. The active purified isolates of Actinomycetes and fungi were identified up to the species level by comparing their morphology of spore bearing hyphae with an entire spore chain and structure of spore chain with the Actinomycetes and fungi morphologies as describe by Bergey’s Manual of Systematic Bacteriology. The Gram-staining method was applied to pure colonies. Briefly, a smear of culture was put on a clean glass slide and heated gently over a flame. The smear was covered with a thin film of crystal violet for one minute and washed gently in slow running tap water. Gram’s iodine solution was flooded over the smear for one minute and washed with tap water. Alcohol was used to decolorize the smear until the violet color ceased to flow away. The slide was then washed with water and counter stain safranine was flooded over the smear for two minutes, after which the slide was washed, drained, air-dried, and viewed under a microscope. A culture retaining the violet color indicated that it is a gram-positive organism [6, 7].
Molecular identification of TP2 strain was carried out based on a partial analysis of the 16S ribosomal RNA of the bacteria. Isolation of DNA was carried out by inoculating the TP2 strain in medium Yeast Starch Agar (YSA), and next incubating it for 48 hours. Mycelia biomass was then harvested for a DNA extraction process. Extraction of genomic DNA of TP2 strain as a template for a polymerase chain reaction (PCR) was carried out using the GES method [6]8, after which the 16S rRNA gene was amplified by PCR. The primary amplification by PCR of 16S rRNA used 9F (5’GAGTTTGATCCTGGCTCAG –3’) and 1541 R (5- AAGGAGGTGATCCAACC –3’) [9]. PCR product purification was carried out by PEG precipitation [10] and continued through a sequencing cycle. The purification of this product was repeated by ethanol purification. The analysis of the nitrogen base sequence was read using an automated DNA sequencer (ABI PRISM 3130 Genetic Analyzer) (Applied Biosystems).
Sequence analysis
The raw data from the sequencing were then trimmed by the MEGA 4 program and assembled by the BioEdit program, and finally converted to the FASTA format. The DNA sequencing data in FASTA format was analyzed using the BLAST program in order to identify the homology using the online resources of NCBI (www. ncbi. nlm. nih. gov) and DDBJ (www. ddbj. nig. ac. jp). The last step of identification was an analysis of the phylogenetic tree using Clustal X program [11] and NJ plot program [12,13].
Antifungal screening by fermentation
The TP1, TP2, TP3, TP4, and TP5 strains were inoculated into fermentation medium, which consisted of soluble starch 1%, glucose 1%, yeast extract 0.5%, tryptone 0.25% and CaCO3 0.1%. This will be referred to as medium A. 50 ml of medium A was prepared in a 250 ml capacity Erlenmeyer flask and then sterilized. 10% of starting inoculum (5-day old culture) were introduced into the sterile broth. The flask was incubated at 280C at 180 rpm for 48 days. After the incubation period, the broth was separated by centrifugation at 4500 rpm for 15 minutes. Cell-free supernatant was applied to the fungal test microbes. The growth inhibition was determined by agar diffusion method [14].
Fermentation condition and extraction of antifungal metabolites
Based on the above results, the fermentation conditions were optimized for TP2 strain. Five liters of medium A were prepared in a 10-liter capacity fermentor and then sterilized. Ten percent of starter inoculum (five-day old culture) was added to 50 ml, then to 500 ml and the remainder to 5 liters of medium A. The culture was incubated at 280C at 180 rpm at pH 7 for 48 hours. After the incubation period, the broth was separated by centrifugation at 4500 rpm for 15 minutes. Cell-free supernatant of TP2 strain was extracted with ethyl acetate. The filtrate and solvent were mixed at a 1:1 (v/v) ratio and the mixture was transferred to a separating funnel and shaken vigorously. Extraction was continued up to three times with the same solvent. The organic layer was collected and solvent was evaporated using a vacuum rotary evaporator at a temperature of 40oC [15,16]. Ethyl acetate extract free from organic solvent was tested with regards to its activities against test microbes. Growth inhibition was determined by agar diffusion, the MIC (minimum inhibitory concentration) (µg/ml) was determined by microdillution method [15,17,18].
Test organisms
The Microsporum gypseum as test organisms was used to test the minimum inhibitory concentration (MIC) and the diameter of inhibition (mm).
RESULTS
Isolation of Actinomycetes and fungi and screening of bioactivity
Three active strains of Actinomycetes and two active strains of fungi were recovered from volcanic soil samples collected from Tangkuban Perahu Mountain (West Java Province, Indonesia) using potato dextrose agar (PDA). The isolated cultures are designated TP1, TP2, TP3, TP4, and TP5. The fermentation broth of the five strains was screened against resistant and pathogenic bacteria, fungi, and T47D cell line. The result of the bioactive screening was that all isolates showed antifungal activities, with the range of diameter of inhibition being: (7-18) mm against M. gypseum, the highest bioactivity was shown by TP2 strain against M. gypseum (18±0.05 mm) (fig. 1). Based on the result, TP2 strain was chosen for further experiment.

Fig. 1: Screening of bioactivity of fermentation broth of TP1, TP2, TP3, TP4, and TP5 strains against M. gypseum Morphological, physiological, biochemical, and molecular characteristics of strains
The study of characteristics of strains covers morphological, physiological, biochemical, and molecular aspects rendered in Tables 1, 2, fig. 2, 3, and 4.
The colors of the substrates mycelium and aerial spore mass were varied. All strains produced diffusible pigments on PDA media. Aerial hyphae of TP2 strain was differentiated into long spiral chains of cylindrical spores but strain TP1 and TP5 had a short chains. The TP2 strain produced long-chain rectiflexible spores. On the other hand, the vegetative hyphae of all isolate branched but not fragmented were detected (fig. 2, and table 1). The utilization and hydrolysis of carbohydrate, nitrogen, protein, and other characteristics are summarized in table 2. Morphological examination (Table 1) and further comparison of physiological and biochemical characteristics among the strains (Table 2) of TP1 to TP5 suggest that TP1 and TP5 belong to Nocardia, TP2 belongs to Streptomyces, TP3 belongs to Aspergillus and TP4 belongs to Paecilomyces.
Analysis of the 16S rRNA gene for Actinomycetes and 18S rRNA or ITS gene for fungi is an important tool for correct identification of microbial species. The BLAST analysis of 16S rRNA gene sequences of strains of TP1, TP2 and TP5, and 18S rRNA or ITS of gene sequences of strains of TP3 and TP4 using the NCBI and DDBJ databases that strains of TP1, TP2, TP3, TP4 and TP5 have the highest similarity with Nocardia sp. YIM 65630GU367167.1 (90%), Streptomyces galbus NR 026178.1(99%), Aspergillus unguis FJ 878626 (86%), Paecilomyces marquandii FJ 765026 (100%), and Nocardia niigatensis NR 043916.1 (95%) (Table 4).
The family and phylogenetic trees of TP2 strain were analyzed using the Clustal X program and the NJ plot program. To construct the phylogenetic trees, the homology sequence from the BLAST and FASTA format results was calculated for the data of three constructions by Clustal X, and then the calculated data were converted into trees with NJ plot. The neighbors-joining (NJ) method is a simple program to construct the phylogenetic tree from evolutionary distance data by finding the pairs of operational taxonomic units (neighbors) that minimize the total branch length at each stage of clustering of neighbors starting with a star-like tree. The phylogenetic trees of 16S rRNA are shown in fig. 4.

Fig. 2: Hypha and chain of spora of TP1 (A), TP2 (B), TP3 (C), TP4 (D) and TP5 (E) strains in PDA medium viewed by the light microscope (100X).
Table 1: Morphology of strains of TP1, TP2, TP3, TP4 and TP5
| S. No. | Strains | Macroscopic colony and microscopic cell characteristics |
| 1 | TP1 | Circular (round), entire, umbonate, moderate colonies, chalk and rough, pigmented, white, dark brown-black reverse, slow growth, the color of young culture is white and the old culture is white/ light-grey. Spore chains are spiral, Gram positive. |
| 2 | TP2 | Circular (round), entire, umbonate, pigmented, heavy grey, light-brown reverse. Cell with long hypha and spore chain with spiral filament. Gram positive, aerial mycelium. |
| 3 | TP3 | The colony growth quickly to green color and white at the edge. Young culture was soft and velvety. Heavy brown to red in reverse. Septa hypha, no cleistothecia, sclerotia and coremia, straight conidiophore. Branch shape at the end of conidiophore and metulae. In metulae reside sterigmata. At the end of sterigmata conidia adhere making a conidia chain, subglubuse conidia and no clamydospora. |
| 4 | TP4 | A light white color, velvety and hairy, septa hypha. Brown reverses, no cleistothecia, sclerotia and coremia. Straight conidiophore. Branch-shape hypha. |
| 5 | TP5 | Circular, entire, umbonate, pigmented, pale white, brown reverse, cell with short hypha and chain with spiral filament. Gram positive. Aerial mycelium. |
Table 2: Physiological and biochemical properties of TP1, TP2 and TP5 strains
| Strain properties | TP1 | TP2 | TP5 |
| Motility | Motile | Motile | Motile |
| Biochemistry assay | |||
| Starch hydrolysis | Positive | Positive | Positive |
| Fat hydrolysis | Negative | Negative | Negative |
| Casein hydrolysis | Positive | Positive | Positive |
| Liquefaction of gelatin | Negative | Negative | Negative |
| Utilize of carbon source | |||
| Inositol | Negative | Negative | Positive |
| Glucose | Positive | Positive | Positive |
| Mannose | Negative | Negative | Positive |
| Sorbitol | Positive | Negative | Positive |
| Fructose | Negative | Negative | Positive |
| Lactose | Negative | Negative | Positive |
| Maltose | Negative | Negative | Positive |
| Galactose | Negative | Negative | Positive |
| Xylosa | Positive | Positive | Positive |
| Sucrose | Negative | Negative | Positive |
| Arabinose | Positive | Positive | Positive |
| Growth in NaCl 10% | Negative | Negative | Negative |
| Production of H2S | Negative | Negative | Negative |
| Production of Indol | Negative | Negative | Negative |
| Degradation of urea | Negative | Negative | Positive |
| Citrate reduction | Negative | Negative | Positive |
| Methyl red | Negative | Negative | Negative |
| Voges Proskauer | Negative | Negative | Negative |
| Simmon’s citrate | Negative | Negative | Negative |
| Growth in 1% of Tryptone broth | Pellicle | Pellicle | Pellicle |
Fig. 3: Production of amylase (a) and protease (b) by TP2 strain

Fig. 4: Phylogeny tree of TP2 strain
Fermentation process and extraction of TP2 strain
During the production of secondary metabolites, monitoring was done to the growth of microbes and measurement was undertaken of the use of sources of carbohydrate and nitrogen. In fig. 5, it can be seen that microbes used glucose as a source of carbon for their growth and formation of antibiotics. This was continued with the use of starch when the glucose ran out. This occurs because glucose has a simple sugar structure so that it can easily be degraded by microbes. The source of nitrogen was degraded last by the microbes for their growth and formation of secondary metabolites. Beginning the 20th hour through the 46th hour, a development of microbes in a stagnant fashion was observed, during which the use of sources of carbon and nitrogen remained constant. Under these circumstances, the microbes entered a phase known as the stationary phase, during which antibiotics are usually formed. The harvesting of secondary metabolites produced by TP2 strain was done at the hour with the highest development, namely the 46th hour, since at the 47th hour the growth slowly decreased, approaching the death phase. At the hour with the highest development, the liquid of fermentation was extracted with the organic solvent ethyl acetate. The extract of ethyl acetate was tested against test microbes. The diameter of inhibition and the MIC value of the ethyl acetate extract of TP2 strain against M. gypseum was36 mm; 4.7 µg/ml (Table 3).
Table 3: Diameter of inhibition (mm), MIC and IC50 (µg/ml) of ethyl acetate extract of TP2 strain
| S. No. | Test of organisms | Diameter of inhibition (mm) | MIC (µg/ml) |
IC50 (µg/ml) |
| 1 | MRSA | 35±0.21 | 150 | - |
| 2 | MSSA | 30±0.36 | 150 | - |
| 3 | MRCNS | 35±0.21 | 300 | - |
| 4 | VRE | 35±0.32 | 300 | - |
| 5 | E. coli | 29±0.37 | 300 | - |
6 7 |
M. gypseum T47D cell line |
36±0.10 - |
4.7 - |
- 457 |
| n = 3 |
DISCUSSION
From the volcanic soil samples collected from Tangkuban Perahu mountain, three Actinomycetes and two fungi were isolated. All of the isolates demonstrated antibiotic biological activities, among which broad-spectrum and narrow-spectrum. The highest activity of five strains against resistant and pathogenic bacteria, and fungi was shown by TP2 strain. Fig. 1 shows that the fermentation broth of TP2 strain had the lowest T47D cell availability (40%) of five isolates, which suggests that TP2 strain has the highest anticancer potential.
DNA sequencing data of five strains was continued in FASTA format using the BLAST program. 16S rRNA or 16S ribosomal RNA is a component of the 30S small subunit of prokaryotic ribosomes. It is 1542 kb (or 1542 nucleotides) in length. The gene coding for it is referred to as 16S rRNA and is used for reconstructing phylogenies [9,12,13]. The results of the homology analysis of the ribosomal DNA of the five strains using 16S rRNA are shown on table 4.
The search for novel metabolites especially from Actinomycetes and fungi requires a large number of isolates in order to discover a novel compound of pharmaceutical interest. The search will be more promising if diverse Actinomycetes and fungi are sampled and screened. For this reason, we focused on Actinomycetes and fungi from volcanic soil expected to produce different types of secondary metabolites and some of these chemical compounds are toxic to soil microorganisms including Actinomycetes and fungi. However, adaptation has led in turn to the Actinomycetes and fungi to produce their own secondary metabolites [19].
The production of metabolite by fermentation process of TP2 strain was done for 46 hours. Metabolites with antibacterial, antifungal, and anticancer activities were induced by the decrease of glucose, protein and starch concentrate in the growth medium. During that time, the microorganism utilized the carbon and nitrogen source for making antibiotics (fig. 5).
The ethyl acetate extract of Streptomyces galbus TP2 strain shows a potential antibacteria (MRSA, MSSA, MRCNS, VRE, E. coli), antifungal (M. gypseum), and anticancer (T47D cell line) activities. Many strains of S. galbus have been shown to be potential agents against fungal pathogens. A non-polyenic structure from S. galbus has been reported to be active against pathogenic fungi [20]. The metabolite from ethyl acetate extract prepared from the Streptomyces galbus novel strain with pesticidal activities against lepidopteran insects has been patented [21]. The results described in this paper indicate that this microorganism can be useful for many applications, such as control of infectious diseases and drug discovery [14].
Table 4: Result of molecular identification of 16S rRNA of strains
| S. No. | Strains | Homology (%) | Accession Number |
1 2 3 4 5 |
Nocardia sp. YIM 65630 TP1 strain Streptomycin galbus TP2 strain Aspergillus unguis TP3 strain Paecilomyces marquandii TP4 strain Nocardia niigatensis TP5 strain |
90 99 88 100 95 |
GU367167.1 NR_026178.1 FJ878626 FJ765026 NR_043916.1 |

Fig. 5: Characterization of TP2 strain in fermentation process for 48 hours, 280C, pH7, 1 vvm, and 180 rpm
CONCLUSION
Ethyl acetate extract of TP2 strain can produce antifungal with MIC of 4.7 µg/ml and diameter of inhibition was 36 ± 0.10 mm.
ACKNOWLEDGEMENT
We would like to thank ITB, RISTEK and LIPI for supporting the financial, facility and infrastructure.
CONFLICT OF INTERESTS
Declared None
REFERENCES
- Berdi J. Bioactive microbial metabolites. J Antibiot 2005;58:1-26.
- Boca Raton FL. Anticancer Agents from Natural Products. 2nd ed. New York, CRC Press; 2005. p. 23-46.
- Wardani IGAAK, Andayani DGS, Sukandar U, Sukandar EY. Study on microbial activity of Nocardia sp. strain TP1 isolated from Tangkuban Perahu soil, West Java, Indonesia. Int J Pharm Pharm Sci 2013;5(2):713-6.
- Andayani DGS, Sukandar EY, Sukandar U, Adnyana IK. Isolation, identification of phenylacetic acid from Streptomyces galbus TP2 strain and its toxicity. Int J Pharm Pharm Sci 2014;6(5):643-6.
- Demain AL, Solomon NA. Manual of Industrial Microbiology and Biotechnology. Washington DC, ASM Press; 1986.
- Holt JG, Krieg NR, Sneath PHA, Staley JT, William ST. Bergey’s Manual of Determinative Bacteriology. Maryland, Williams and Wilkins, 9thed; 1994.
- Cappuccino JG, Sherman N. Microbiology, A Laboratory Manual. San Francisco, Pearson Benjamin Cummings, 8th ed; 2005.
- Pitcher DG, Saunders NA, Owen RJ. Rapid extraction of bacterial genomic DNA with guanidiumthiocyanate. Lett Appl Microbiol 1989;8:109-14.
- Hiraishi A, Kamagata Y, Nakamura N. Polymerase chain reaction amplification and restriction fragment length polymorphism analysis of 16S rRNA genes from methanogens. Ferment Bioeng 1995;79:523-9.
- Tamura T, Hayakawa M, Hatano K. A new genus of the order actinomycetales, spidliplanesgen. nov with description of Spirilliiplanesyamanashiensis sp nov. Int J Syst Bacteriol 1997;97-102.
- Thompson JD, Gibson TJ, Plewniak F, Higgins DG. Clustal X windows interface: flexible strategies for multiple sequence alignment aided by quality analysis tools. J Nucleic Acids Res 1997;25:4876-82.
- Felsenstein J. Confidence limitson phylogenies: an approach using the bootstrap. J Organism Evolution 1985;39:783-9.
- Saitou N, Nei M. The neighbor-joining method: a new method for reconstruction phylogenetic tree. J Mol Biol Evol 1987;4:406-25.
- Sukandar EY, Sastramihardja I, Padmawinata K, Satiadarma K. Microbial utilization of renewable resources. JSPS-NRCT Seminar Biotechnol 1984;4:244-51.
- Michael LS, Fikret K. Bioprocess Engineering. New York, Prentice Hall International Series in the Physical and Chemical Engineering Sciences. 2nd ed; 2002.
- Satyajit DS, Zahid L, Alexander IG. Natural Products Isolation. New Jersey, Humana Press, 2nd ed; 2006.
- Mosmann T. Rapid colorimetric assay for cellular growth & survival, Application to proliferation & cytotoxicity assays. J Immunol Method 1983;65:65-59.
- Freimoser FM, Jakob CA, Aebi M, Tuor U. The MTT 3-(4,5-Dimethylthiazol-2-yl)-2,5-Diphenyltetrazolium Bromide assay is a fast and reliable method for colorimetric determination of fungal cell densities. Appl Environ Microbiol 1999;65:3727-9.
- Omura S. The search for bioactive compounds from microorganism. Berlin, Springer; 1992.
- Paul AK, Banerjee AK. A new antifungal antibiotic produced by Streptomyces galbus. Folia Microbiol 1983;28:386-96.
- Streptomyces galbus strain with insecticidal activity and method of using as an insecticide. Europesn Patent EP1272611.